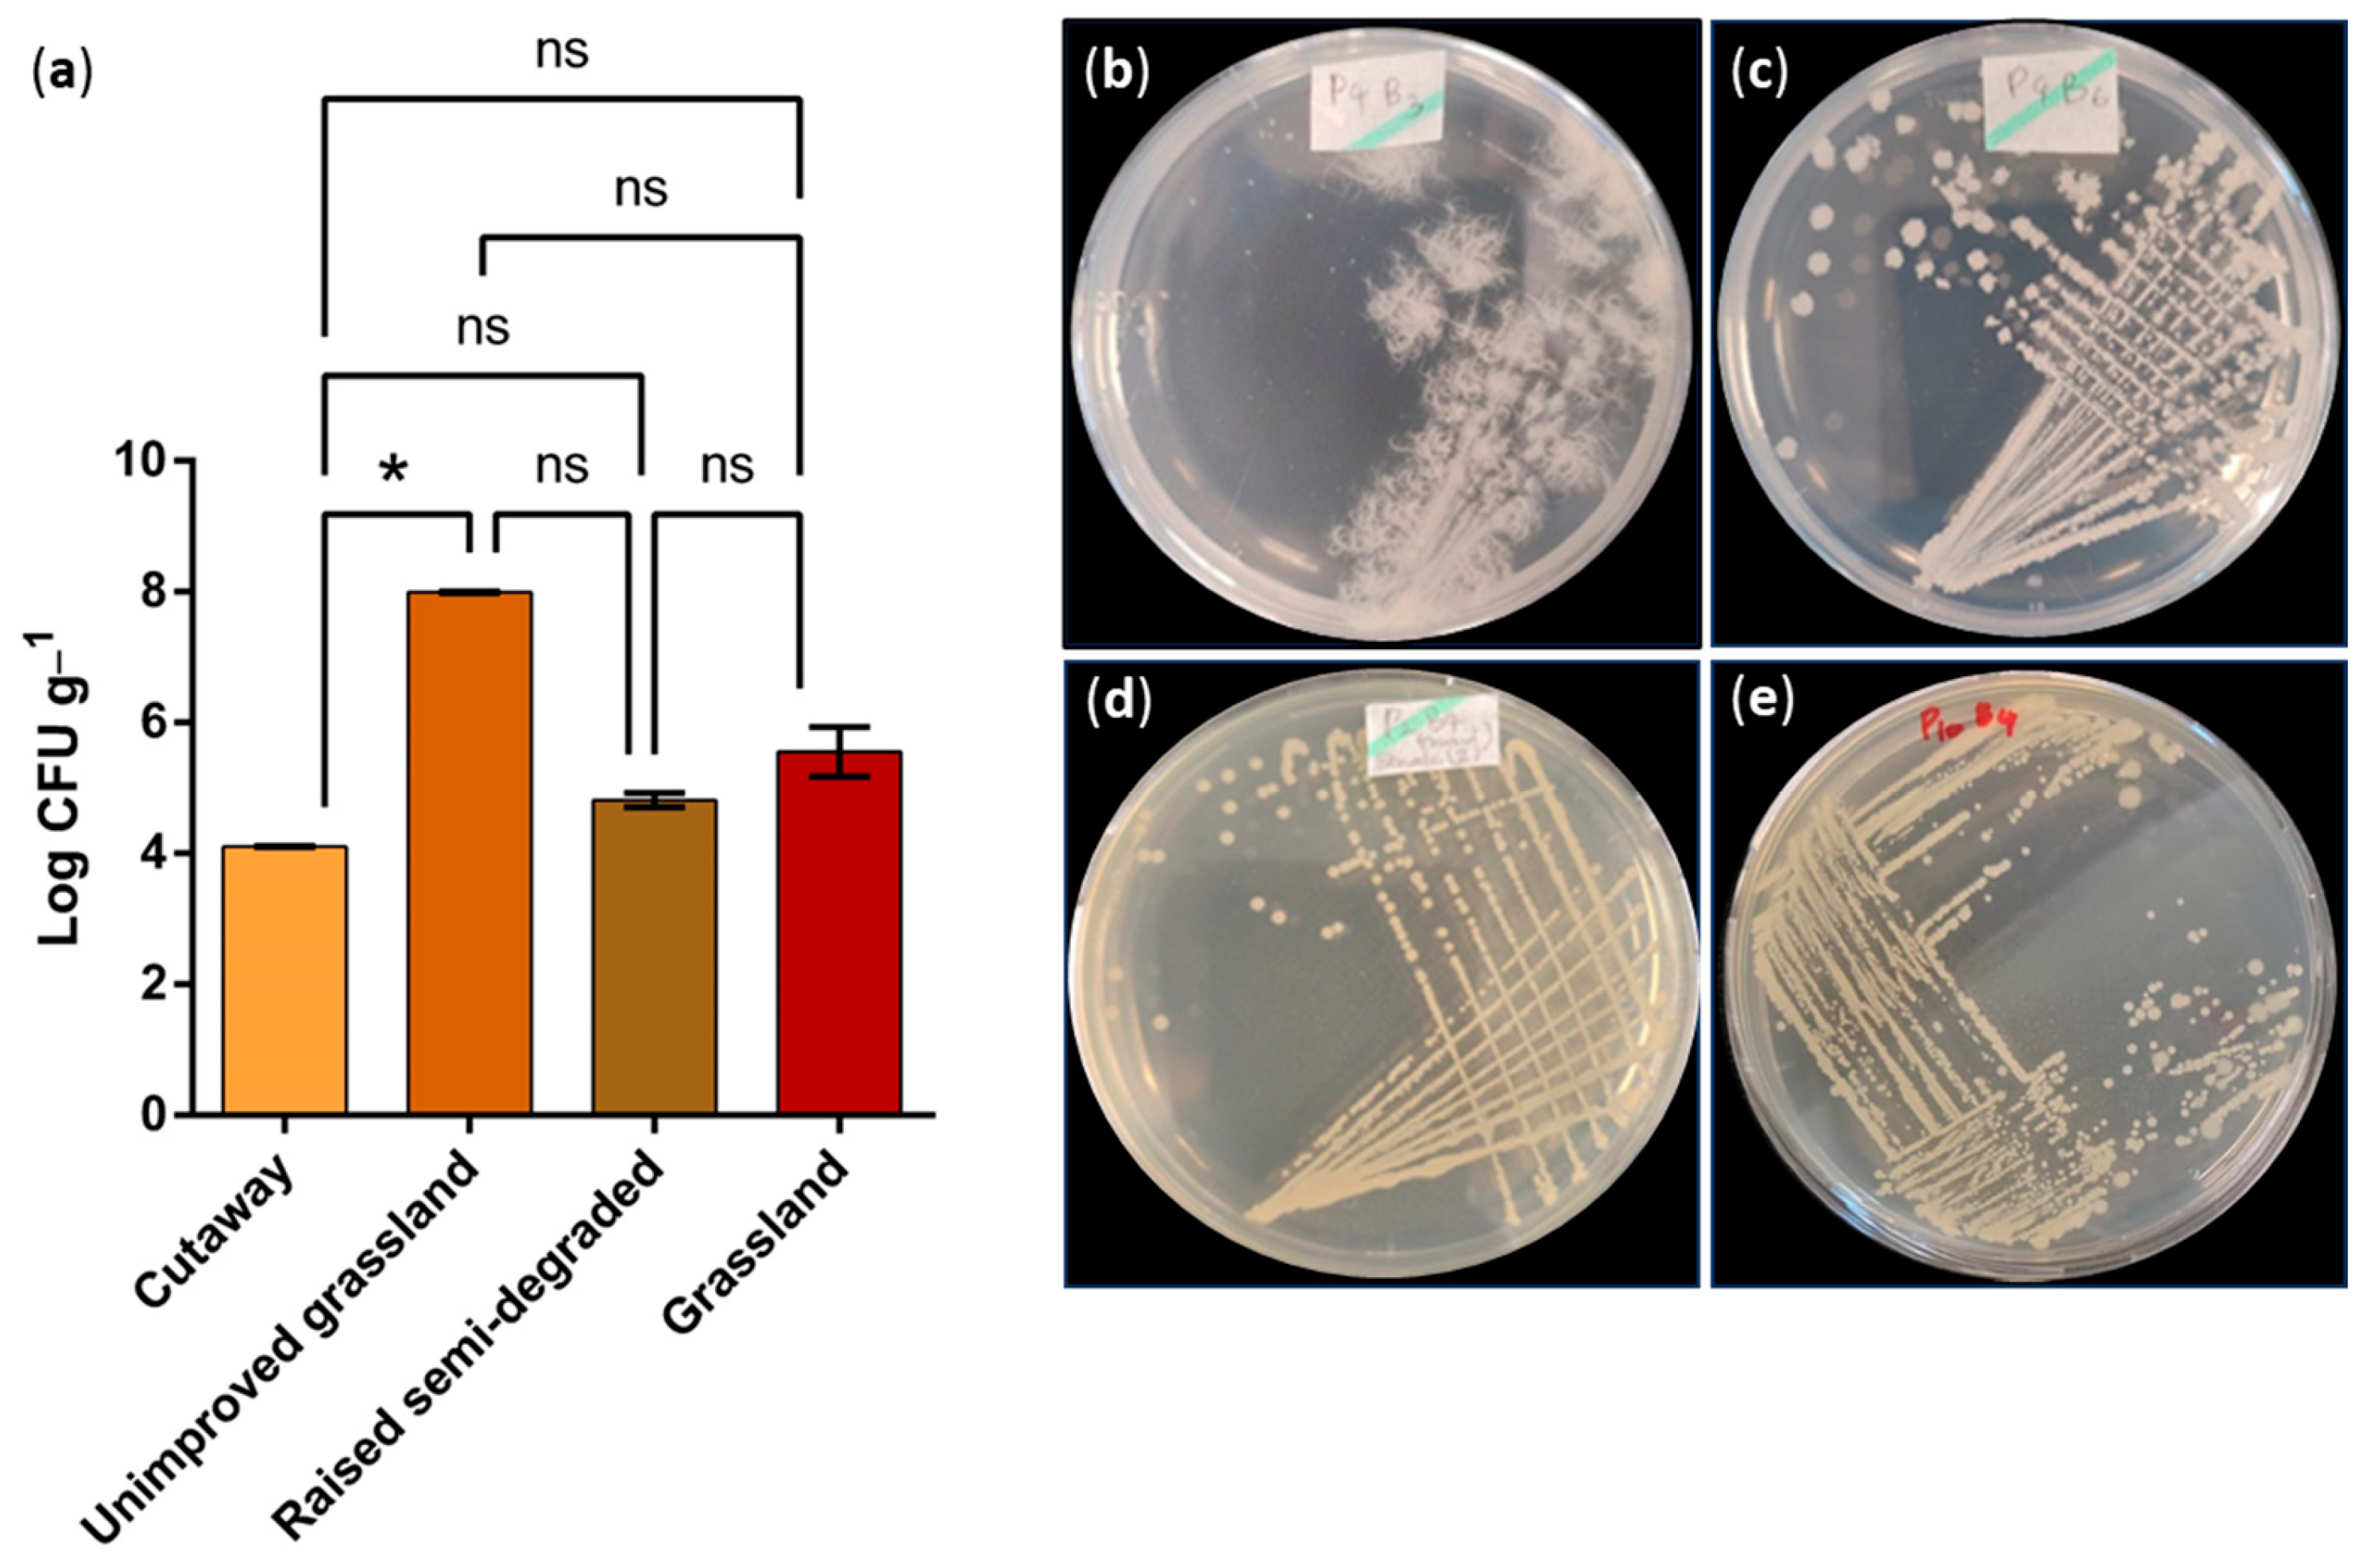

Effect of ‘Peatland-Use’ Type on Culturable Microbial Groups in Irish Peatlands in the Midlands
Abstract
:1. Introduction
2. Materials and Methods
2.1. Sample Sites and ‘Peatland-Use’ Types
2.2. Sample Collection
2.3. Isolation of Distinct Groups of Culturable Microorganisms
2.3.1. Isolation and Enumeration of the Total Viable Bacteria (TVB) and Aerobic Bacteria (AB)
2.3.2. Isolation and Enumeration of the Culturable Fungal Population
2.3.3. Isolation and Enumeration of Anaerobic Bacteria
2.3.4. Isolation of Phosphate-Solubilizing Bacteria (PSB)
2.3.5. Isolation of Actinomycetes
2.3.6. Glycerol Stock Preparation
2.4. Measuring the Soil pH
2.5. Statistical Analysis
3. Results
3.1. Total Viable Bacterial (TVB) Counts across Vegetation Patterns
3.2. Comparison of TVB and Aerobic Bacterial (AB) Counts and the AB/TVB Ratio
3.3. Morphology of Bacteria under Light Microscopy
3.4. Fungal Populations
3.5. Enumeration of Anaerobes across the Vegetation Types
3.6. Phosphate-Solubilizing Bacteria (PSB) and Phosphate-Solubilizing Index (PSI)
3.7. Detection and Isolation of Actinomycetes
4. Discussion
5. Conclusions
Supplementary Materials
Author Contributions
Funding
Data Availability Statement
Acknowledgments
Conflicts of Interest
References
- Connolly, J.; Holden, N.M. Mapping Peat Soils in Ireland: Updating the Derived Irish Peat Map. Ir. Geogr. 2009, 42, 343–352. [Google Scholar] [CrossRef]
- Bourgeau-Chavez, L.L.; Endres, S.L.; Graham, J.A.; Hribljan, J.A.; Chimner, R.A.; Lillieskov, E.A.; Battaglia, M.J. Mapping peatlands in boreal and tropical ecoregions. In Reference Module in Earth Systems and Environmental Sciences; Liang, S., Ed.; Comprehensive Remote Sensing: Oxford, UK, 2017; Volume 6, pp. 1–9. ISBN 9780128032206. [Google Scholar]
- Artz, R.R.E.; Anderson, I.C.; Chapman, S.J.; Hagn, A.; Schloter, M.; Potts, J.M.; Campbell, C.D. Changes in Fungal Community Composition in Response to Vegetational Succession During the Natural Regeneration of Cutover Peatlands. Microb. Ecol. 2007, 54, 508–522. [Google Scholar] [CrossRef]
- Wilson, D.; Müller, C.; Renou-Wilson, F. Carbon Emissions and Removals from Irish Peatlands: Present Trends and Future Mitigation Measures. Ir. Geogr. 2013, 46, 1–23. [Google Scholar] [CrossRef]
- Feehan, J.; O’Donovan, G.; Renou-Wilson, F.; Wilson, D. The Bogs of Ireland: An Introduction to the Natural, Cultural and Industrial Heritage of Irish Peatlands; University College Dublin: Dublin, Ireland, 2008; pp. 1–112. [Google Scholar]
- Renou-Wilson, F.; Bloger, T.; Bullocj, C.; Covery, F.; Curry, J.; Ward, S.; Wilson, D.; Muller, C. BOGLAND: Sustainable Management of Peatlands in Ireland: Protocol Document; University College Dublin: Dublin, Ireland, 2011. [Google Scholar]
- Farrell, C.; Feehan, J. International Peat Society; Irish Peat Society. After wise use: The future of peatlands. In Proceedings of the 13th International Peat Congress, Tullamore, Ireland, 8–13 June 2008. [Google Scholar]
- Frolking, S.; Roulet, N.T. Holocene Radiative Forcing Impact of Northern Peatland Carbon Accumulation and Methane Emissions. Glob. Chang. Biol. 2007, 13, 1079–1088. [Google Scholar] [CrossRef]
- Wilson, D.; Farrell, C.; Mueller, C.; Hepp, S.; Renou-Wilson, F. Rewetted Industrial Cutaway Peatlands in Western Ireland: A Prime Location for Climate Change Mitigation? Mires Peat 2013, 11, 1–12. [Google Scholar]
- Offermanns, L.; Tiemeyer, B.; Dettmann, U.; Rüffer, J.; Düvel, D.; Vogel, I.; Brümmer, C. High Greenhouse Gas Emissions after Grassland Renewal on Bog Peat Soil. Agric. For. Meteorol. 2023, 331, 109309. [Google Scholar] [CrossRef]
- Pschenyckyj, C.; Donahue, T.; Kelly-Quinn, M.; O’Driscoll, C.; Renou-Wilson, F. An Examination of the Influence of Drained Peatlands on Regional Stream Water Chemistry. Hydrobiologia 2023, 850, 3313–3339. [Google Scholar] [CrossRef]
- Graça, J.; Daly, K.; Bondi, G.; Ikoyi, I.; Crispie, F.; Cabrera-Rubio, R.; Cotter, P.D.; Schmalenberger, A. Drainage Class and Soil Phosphorus Availability Shape Microbial Communities in Irish Grasslands. Eur. J. Soil Biol. 2021, 104, 103297. [Google Scholar] [CrossRef]
- Laine, A.; Wilson, D.; Kiely, G.; Byrne, K.A. Methane Flux Dynamics in an Irish Lowland Blanket Bog. Plant Soil 2007, 299, 181–193. [Google Scholar] [CrossRef]
- Moore, J.J.; Dowding, P.; Healy, B. Glenamoy, Ireland. In Proceedings of the 5th International Meeting on Biological Productivity of Tundra: IBP Tundra Biome, Abisko, Sweden, 16–24 April 1974. [Google Scholar]
- Deering, L.; Doohan, F.; Clipson, N. The effects of restoration on bacterial community structure in a montane blanket bog. In Proceedings of the 13th International Peat Congress: Pristine Mire Landscapes, Tullamore, Ireland, 8–13 June 2008. [Google Scholar]
- Healy, M.G.; Siggins, A.; Molloy, K.; Potito, A.P.; O’leary, D.; Daly, E.; Callery, O. The Impact of Alternating Drainage and Inundation Cycles on Geochemistry and Microbiology of Intact Peat Cores. Sci. Total Environ. 2022, 858, 159664. [Google Scholar] [CrossRef]
- Murphy, B.P.M. Non-Symbiotic Nitrogen-Fixing Bacteria in Irish Soils. PRIA 1975, 75, 453–464. [Google Scholar]
- McKeon-Bennett, M.M.P.; Hodkinson, T.R. Sphagnum Moss as a Novel Growth Medium in Sustainable Indoor Agriculture Systems. Curr. Opin. Environ. Sci. Health 2021, 22, 100269. [Google Scholar] [CrossRef]
- Galand, P.E.; Saarnio, S.; Fritze, H.; Yrjälä, K. Depth Related Diversity of Methanogen Archaea in Finnish Oligotrophic Fen. FEMS Microbiol. Ecol. 2002, 42, 441–449. [Google Scholar] [CrossRef] [PubMed]
- Birnbaum, C.; Wood, J.; Lilleskov, E.; Lamit, L.J.; Shannon, J.; Brewer, M.; Grover, S. Degradation Reduces Microbial Richness and Alters Microbial Functions in an Australian Peatland. Microb. Ecol. 2023, 85, 875–891. [Google Scholar] [CrossRef]
- Atapattu, G.N.; Battersby, T.; Giltrap, M.; Tian, F. Do the Culturable Microbial Groups Present in Cutaway Bogs Change According to Temporal Variation? Pilot Study Based on the Midlands in the Republic of Ireland. Appl. Microbiol. 2023, 3, 297–311. [Google Scholar] [CrossRef]
- Andersen, R.; Farrell, C.; Graf, M.; Muller, F.; Calvar, E.; Frankard, P.; Caporn, S.; Anderson, P. An Overview of the Progress and Challenges of Peatland Restoration in Western Europe. Restor. Ecol. 2017, 25, 271–282. [Google Scholar] [CrossRef]
- Grassland—British Habitats—Woodland Trust. Available online: https://www.woodlandtrust.org.uk/trees-woods-and-wildlife/habitats/grassland/ (accessed on 13 July 2023).
- Huotari, N.; Tillman-Sutela, E.; Kauppi, A.; Kubin, E. Fertilization Ensures Rapid Formation of Ground Vegetation on Cut-Away Peatlands. Can. J. For. Res. 2007, 37, 874–883. [Google Scholar] [CrossRef]
- EUNIS—Factsheet for Degraded Raised Bogs Still Capable of Natural Regeneration. Available online: https://eunis.eea.europa.eu/habitats/10143 (accessed on 13 July 2023).
- Gams, W.; Bissett, J. Morphology and identification of trichoderma. In Trichoderma and Gliocladium. Basic Biology, Taxonomy and Genetics, 1st ed.; Harman, G.E., Kubicek, C.P., Eds.; Taylor and Francis: London, UK, 1998; pp. 3–34. [Google Scholar]
- Massee, G. Text Book of Fungi; Duckworth and Co.: London, UK, 1910; pp. 63–171. [Google Scholar]
- Lee, J.W.; Hwang, E.; Kacker, R.N. True Value, Error, and Measurement Uncertainty: Two Views. Accredit. Qual. Assur. 2022, 27, 235–242. [Google Scholar] [CrossRef]
- Elliott, D.R.; Caporn, S.J.M.; Nwaishi, F.; Nilsson, R.H.; Sen, R. Bacterial and Fungal Communities in a Degraded Ombrotrophic Peatland Undergoing Natural and Managed Re-Vegetation. PLoS ONE 2015, 10, e0124726. [Google Scholar] [CrossRef]
- Grayston, S.J.; Griffith, G.S.; Mawdsley, J.L.; Campbell, C.D.; Bardgett, R.D. Accounting for Variability in Soil Microbial Communities of Temperate Upland Grassland Ecosystems. Soil Biol. Biochem. 2001, 33, 533–551. [Google Scholar] [CrossRef]
- Irish Peatland Conservation Council. Available online: http://www.ipcc.ie/advice/peatland-management-diy-tool-kit/restoration-of-industrial-cutaway-peatlands/ (accessed on 8 July 2022).
- Wang, K.; Pan, R.; Fei, H.; Tong, Q.; Han, F. Changes in Soil Prokaryotic Communities and Nitrogen Cycling Functions along a Groundwater Table Drawdown Gradient in Desert Wetlands. Sci. Total Environ. 2022, 842, 156868. [Google Scholar] [CrossRef] [PubMed]
- Chaikitkaew, S.; In-Chan, S.; Singkhala, A.; Tukanghan, W.; Mamimin, C.; Reungsang, A.; Birkeland, N.K.; O-Thong, S. Clostridium Thailandense sp. Nov., a Novel CO2-Reducing Acetogenic Bacterium Isolated from Peatland Soil. Int. J. Syst. Evol. Microbiol. 2022, 72, 005254. [Google Scholar] [CrossRef]
- Urbanová, Z.; Bárta, J. Recovery of Methanogenic Community and Its Activity in Long-Term Drained Peatlands after Rewetting. Ecol. Eng. 2020, 150, 105852. [Google Scholar] [CrossRef]
- Chroňáková, A.; Bárta, J.; Kaštovská, E.; Urbanová, Z.; Picek, T. Spatial Heterogeneity of Belowground Microbial Communities Linked to Peatland Microhabitats with Different Plant Dominants. FEMS Microbiol. Ecol. 2019, 95, fiz130. [Google Scholar] [CrossRef]
- Andrus, R.E. Some Aspects of Sphagnum Ecology. Can. J. Bot. 2011, 64, 416–426. [Google Scholar] [CrossRef]
- Hii, Y.S.; Yen San, C.; Lau, S.W.; Danquah, M.K. Isolation and Characterisation of Phosphate Solubilizing Microorganisms from Peat. Biocatal. Agric. Biotechnol. 2020, 26, 101643. [Google Scholar] [CrossRef]
- Istina, I.N.; Widiastuti, H.; Joy, B.; Antralina, M. Phosphate-Solubilizing Microbe from Saprists Peat Soil and Their Potency to Enhance Oil Palm Growth and P Uptake. Procedia Food Sci. 2015, 3, 426–435. [Google Scholar] [CrossRef]
- Oraee, A.; Tehranifar, A.; Karimpour, S. Possibility of Producing Tulip Bulblet under Drought Stress Using Potassium and Phosphorus Solubilizing Bacteria. Commun. Soil Sci. Plant Anal. 2022, 54, 819–835. [Google Scholar] [CrossRef]
- Park, K.H.; Lee, O.M.; Jung, H.I.; Jeong, J.H.; Jeon, Y.D.; Hwang, D.Y.; Lee, C.Y.; Son, H.J. Rapid Solubilization of Insoluble Phosphate by a Novel Environmental Stress-Tolerant Burkholderia Vietnamiensis M6 Isolated from Ginseng Rhizospheric Soil. Appl. Microbiol. Biotechnol. 2010, 86, 947–955. [Google Scholar] [CrossRef] [PubMed]
- Li, Q.; Chen, X.; Jiang, Y.; Jiang, C. Morphological identification of actinobacteria. In Actinobacteria—Basics and Biotechnological Applications; Dhanasekaran, D., Jiang, Y., Eds.; IntechOpen: London, UK, 2016; pp. 59–86. [Google Scholar]
- Teo, W.F.A.; Lipun, K.; Srisuk, N.; Duangmal, K. Amycolatopsis acididurans sp. Nov., Isolated from Peat Swamp Forest Soil in Thailand. J. Antibiot. 2021, 74, 199–205. [Google Scholar] [CrossRef]
- Chantavorakit, T.; Klaysubun, C.; Duangmal, K. Streptomyces acididurans sp. Nov., Isolated from Peat Swamp Forest Soil. Int. J. Syst. Evol. Microbiol. 2021, 71, 004849. [Google Scholar] [CrossRef] [PubMed]
- Zhao, M.; Wang, M.; Zhao, Y.; Wang, G.; Xue, Z.; Jiang, M. Variations in Soil Microbial Communities in the Sedge-Dominated Peatlands along an Altitude Gradient on the Northern Slope of Changbai Mountain, China. Ecol. Indic. 2021, 129, 107964. [Google Scholar] [CrossRef]
- Zaitlin, B.; Turkington, K.; Parkinson, D.; Clayton, G. Effects of Tillage and Inorganic Fertilizers on Culturable Soil Actinomycete Communities and Inhibition of Fungi by Specific Actinomycetes. Appl. Soil Ecol. 2004, 26, 53–62. [Google Scholar] [CrossRef]
- Müller, K.; Marhan, S.; Kandeler, E.; Poll, C. Carbon Flow from Litter through Soil Microorganisms: From Incorporation Rates to Mean Residence Times in Bacteria and Fungi. Soil Biol. Biochem. 2017, 115, 187–196. [Google Scholar] [CrossRef]

| Land-Use Types | Average pH of the Peat Soil | Temperature (°C) |
|---|---|---|
| Cutaway | 5.35 ± 0.04 | 6 |
| Unimproved grassland | 6.19 ± 0.07 | 7 |
| Raised semi-degraded | 4.52 ± 0.1 | 6 |
| Grassland | 6.08 ± 0.06 | 7 |
| Study Site | Average Diameter of the Colony (cm) | Average Diameter of the Colony + Halozone (cm) | Phosphate Solubilization Index (PSI) |
|---|---|---|---|
| Cutaway | 0.5 ± 0.1 | 1.5 ± 0.1 | 3.000 |
| Cutaway | 0.6 ± 0.1 | 1.9 ± 0.1 | 3.167 |
| Cutaway | 1.25 ± 0.1 | 2 ± 0.1 | 1.6 |
| Unimproved | 0.5 ± 0.1 | 0.7 ± 0.1 | 1.4 |
| Unimproved | 0.55 ± 0.1 | 0.95 ± 0.1 | 1.727 |
| Grassland | 1.1 ± 0.1 | 1.55 ± 0.1 | 1.409 |
| Grassland | 0.5 ± 0.1 | 0.8 ± 0.1 | 1.600 |
| Grassland | 0.4 ± 0.1 | 0.65 ± 0.1 | 1.625 |
Disclaimer/Publisher’s Note: The statements, opinions and data contained in all publications are solely those of the individual author(s) and contributor(s) and not of MDPI and/or the editor(s). MDPI and/or the editor(s) disclaim responsibility for any injury to people or property resulting from any ideas, methods, instructions or products referred to in the content. |
© 2023 by the authors. Licensee MDPI, Basel, Switzerland. This article is an open access article distributed under the terms and conditions of the Creative Commons Attribution (CC BY) license (https://creativecommons.org/licenses/by/4.0/).
Share and Cite
Atapattu, G.; Obeng, S.A.; Battersby, T.; Giltrap, M.; Tian, F. Effect of ‘Peatland-Use’ Type on Culturable Microbial Groups in Irish Peatlands in the Midlands. Land 2023, 12, 1614. https://doi.org/10.3390/land12081614
Atapattu G, Obeng SA, Battersby T, Giltrap M, Tian F. Effect of ‘Peatland-Use’ Type on Culturable Microbial Groups in Irish Peatlands in the Midlands. Land. 2023; 12(8):1614. https://doi.org/10.3390/land12081614
Chicago/Turabian StyleAtapattu, Gouri, Samuel Apori Obeng, Tara Battersby, Michelle Giltrap, and Furong Tian. 2023. "Effect of ‘Peatland-Use’ Type on Culturable Microbial Groups in Irish Peatlands in the Midlands" Land 12, no. 8: 1614. https://doi.org/10.3390/land12081614
APA StyleAtapattu, G., Obeng, S. A., Battersby, T., Giltrap, M., & Tian, F. (2023). Effect of ‘Peatland-Use’ Type on Culturable Microbial Groups in Irish Peatlands in the Midlands. Land, 12(8), 1614. https://doi.org/10.3390/land12081614

